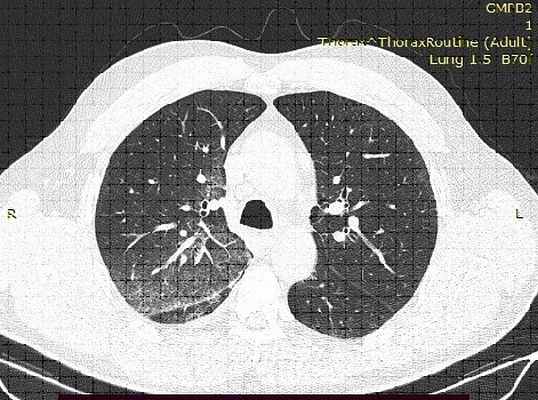
КТ-картина имбибиции верхней доли правого легкого

Носовое кровотечение. Кровохарканье, легочное кровотечение.
Добавил пользователь Валентин П. Обновлено: 03.01.2026
Кровохарканье – это выделение крови с мокротой из дыхательных путей. Критерием массивного кровохарканья является выделение ≥ 600 мл крови в течение 24 часов.
Патофизиология кровохарканья
Большая часть крови (95%) поступает к легким по сосудам с низким давлением (легочным артериям) и достигает легочного капиллярного русла, где происходит газообмен. Около 5% крови циркулирует по сосудам с высоким давлением (бронхиальным артериям), которые кровоснабжают основные дыхательные пути и поддерживающие структуры. При кровохарканье кровь поступает из бронхиальных артерий, за исключением тех случаев, когда легочные артерии повреждаются при травме, эрозии гранулематозного или кальцинированного лимфатического узла или опухоли, редко – при катетеризации легочной артерии или воспалительном поражении легочных капилляров.
Этиология кровохаркания
Мокрота с прожилками крови встречается при многих респираторных заболеваниях, например при инфекции верхних дыхательных путей и вирусном бронхите.
Дифференциальный диагноз включает большое количество нозологий (см. таблицу Причины кровохарканья Причины кровохарканья ).
У взрослых причинами кровохарканья в 70-90% случаев являются:
Первичный рак легкого Обзор опухолей легких (Overview of Lung Tumors) Опухоли легких могут быть Первичный Результат метастазирования из других локализаций в организме Первичные опухоли легких могут быть: Злокачественными (смотри таблицу Классификация первичных. Прочитайте дополнительные сведения является основной причиной у курильщиков ≥ 40 лет, однако метастазы редко вызывают кровохарканье. Причиной кровохарканья все чаще становится аспергиллезная инфекция (Aspergillus) с формированием каверн, однако реже, чем рак легкого.
У детей основными причинами кровохарканья являются:
инфекции нижних дыхательных путей,
Массивное кровохарканье
Основные причины массивного кровохарканья со временем изменились и отличаются в разных географических зонах, но включают следующие:
туберкулезная Туберкулез (ТБ) Туберкулез (ТБ) является хронической прогрессирующей микобактериальной инфекцией, часто имеющей латентный период после начального инфицирования. Чаще всего ТБ поражает легкие. Симптомы включают. Прочитайте дополнительные сведенияОбследование при кровохаркании
Анамнез
История настоящего заболевания включает продолжительность (острое начало, циклическое повторение), провоцирующие факторы (аллергены, холодный воздух, физическая нагрузка, горизонтальное положение), приблизительное количество крови при кровохарканье (отдельные прожилки, чайная ложка, стакан). Ключевая цель состоит в том, чтобы отличить истинное кровохарканье от ложного – рвоты с кровью или от кровотечения из носоглотки. Ощущение постназального затека или кровотечение из носовых ходов без кашля указывает на ложное кровохарканье. При рвоте с кровью рвотные массы имеют характерный цвет кофейной гущи. На истиннное кровохарканье указывает пенистая мокрота, выделение алой крови и ощущение поперхивания.
Исследование систем организма должно быть направлено на поиск признаков, которые указывают на возможную причину кровохарканья: лихорадка и наличие мокроты ( пневмония Обзор пневмонии (Overview of Pneumonia) Пневмония – это острое инфекционное воспаление легких. Первоначальный диагноз ставится на основании данных рентгенографии органов грудной клетки и клинических исследований. Причины, симптомы. Прочитайте дополнительные сведения ); ночная потливость, снижение массы тела и усталость (рак, туберкулез Туберкулез (ТБ) Туберкулез (ТБ) является хронической прогрессирующей микобактериальной инфекцией, часто имеющей латентный период после начального инфицирования. Чаще всего ТБ поражает легкие. Симптомы включают. Прочитайте дополнительные сведения ); боль и отеки ног (тромбоэмболия легочной артерии); гематурия ( синдром Гудпасчера Синдром Гудпасчера Синдром Гудпасчера, разновидность легочно-почечного синдрома, является аутоиммунным синдромом, включающим альвеолярное кровотечение и гломерулонефрит, вызванный циркулирующими антителами к гломерулярной. Прочитайте дополнительные сведения ).
Всех пациентов следует опросить на предмет факторов риска развития причин. К факторам риска относятся: ВИЧ-инфекция, использование иммунодепрессантов (туберкулез, грибковая инфекция); контакт с туберкулезным больным; длительное курение (рак); иммобилизация после операции, рак, тромбозы в анамнезе или у родственников, беременность, использование препаратов, содержащих эстроген , поездка на большие расстояния (тромбоэмболия легочной артерии).
Анамнез перенесенных заболеваний включает заболевания, которые могут вызвать кровохарканье: хронические заболевания легких ( ХОБЛ Хроническая обструктивная болезнь легких (ХОБЛ) Хроническая обструктивная болезнь легких (ХОБЛ) – ограничение воздушного потока, вызванное воспалительным ответом на вдыхаемые токсины, чаще всего сигаретный дым. Менее распространенными причинами. Прочитайте дополнительные сведения , туберкулез, муковисцидоз Муковисцидоз Муковисцидоз является наследственным заболеванием желез внешней секреции, проявляется в первую очередь патологией со стороны желудочно-кишечного тракта и дыхательной системы. Повышенная вязкость. Прочитайте дополнительные сведения , аневризма грудной аорты Аневризмы грудного отдела аорты Увеличение грудной аорты ≥ 50% от нормы обычно указывает на аневризму (нормальный диаметр варьирует в зависимости от местоположения). Большинство аневризм грудного отдела аорты не вызывает симптомов. Прочитайте дополнительные сведения , гранулематоз с полиангиитом). Следует обратить внимание на контакт с туберкулезными больными, особенно у пациентов с ВИЧ-инфекцей или другим иммунодефицитом.
Частые носовые кровотечения, склонность к образованию гематом, заболевания печени указывают на коагулопатию. Следует обратить внимание на прием антикоагулянтов и антиагрегантов.
Объективное обследование
При оценке жизненно важных функций следует обратить внимание на наличие лихорадки, тахикардии, тахипноэ и низкой сатурации кислорода. Также имеют значение системные симптомы (например, кахексия) и степень дыхательной недостаточности (участие дополнительных групп мышц в акте дыхания, дыхание через сжатые губы, ажитация, угнетения сознания).
Проводится осмотр шейных вен, пальпация ног и паховой области на предмет отеков (набухание шейных вен и отеки свидетельствуют о наличии сердечной недостаточности). При аускультации следует обратить внимание на звучность тонов сердца и наличие шумов, которые могут подтвердить диагноз сердечной недостаточности и легочной гипертензии.
При пальпации живота следует обратить внимание на состояние печени: увеличение печени или наличие дополнительных образований указывает на рак или варикозно расширенные вены пищевода, которые могут быть источником кровотечения.
Обследование кожи и слизистых оболочек проводится на предмет экхимозов, петехий, телеангиэктазий, гингивита или признаков кровотечени из полости рта или носа.
Если в момент обследования наблюдается эпизод кровохарканья, необходимо оценить цвет и количество крови.
Тревожные симптомы
Тревожными являются следующие симптомы:
наличие катетера в легочной артерии или трахеостомии,
недомогание, снижение массы тела или усталость,
Длительный стаж курения
одышка в покое, отсутствие или ослабление дыхания
Интерпретация результатов
Данные анамнеза и объективного обследования позволяют предположить диагноз и выбрать алгоритм действий (см. таблицу Причины кровохарканья Причины кровохарканья ).
Несмотря на многочисленные вариации, могут быть сделаны некоторые обобщения. При отсутствии хронических заболеваний, патологии при объективном обследовании и факторов риска (туберкулеза, тромбоэмболии легочной артерии), при остром начале заболевания с кашля и лихорадки кровохарканье, скорее всего, обусловлено ОРВИ; хронические заболевания маловероятны. Однако при наличии факторов риска следует заподозрить соответствующие заболевания. Для оценки риска тромбоэмболии легочной артерии Тромбоэмболия Легочной Артерии (ТЭЛА) Тромбоэмболия легочной артерии – это окклюзия легочных артерий тромбами любого происхождения, чаще всего образующихся в крупных венах ног или малого таза. Факторами риска тромбоэмболии легочной. Прочитайте дополнительные сведенияЕсли кровохарканье обусловлено заболеваниями легких (например, ХОБЛ, муковисцидоз, бронхоэктазы) или сердечно-сосудистой системы (сердечная недостаточность), то у таких пациентов зачастую имеется соответствующий анамнез. Кровохарканье не является начальным проявлением болезни.
У пациентов с иммунодефицитом кровохарканье может быть обусловлено туберкулезом или грибковой инфекцией.
При наличии симптомов хронического заболевания в отсутствие соответствующего анамнеза следует заподозрить рак или туберкулез, хотя кровохарканье может быть первым симптомом рака легкого у пациентов без иных симптомов.
Некоторые специфические симптомы являются важными:
Почечная недостаточность или гематурия в анамнезе даёт основания предполагать наличие легочно-почечного синдрома (например, синдром Гудпасчера, гранулематоз с полиангиитом).
У больных гранулематозом с полиангиитом наблюдаются поражения слизистой оболочки полости носа.
Видимые телеангиэктазии указывают на артериовенозные мальформации.
Пациенты с кровохарканьем, вследствие нарушение свертываемости крови, как правило, имеют кожные признаки (точечные кровоизлияния, геморрагическая сыпь или оба симптома) либо длительно употребляют антикоагулянтные или антитромбоцитарные препараты.
Рецидивирующее кровохарканье, совпадающее с менструацией, указывает на высокую вероятность легочного эндометриоза.
Обследование
Перед взятием анализов пациенты с тяжелым кровохарканьем нуждаются в лечении и стабилизации состояния обычно в условиях отделения интенсивной терапии. При незначительным кровохарканье пациенты могут обследоваться амбулаторно.
При этом всегда проводится визуализация, обычно это рентгенография органов грудной клетки, хотя иногда (например, при имеющихся в анамнезе бронхоэктазах) первичным исследованием является КТ. Пациентам с нормальными результатами, соответствующим анамнезом и незначительным кровохарканьем эмпирически назначают лечение по поводу бронхита. При наличии патологических изменений на рентгенограмме и отсутствии характерного анамнеза проводится КТ и бронхоскопия. КТ позволяет выявить поражения легких, которые не удается диагностировать при рентгенографии, и определить их локализацию для последующей бронхоскопии и биопсии. КТ-ангиография или, реже, вентиляционно-перфузионная сцинтиграфия и/или ангиопульмонография позволяют подтвердить диагноз легочной эмболии. КТ и ангиография легких также могут выявить артериовенозные фистулы в легких.
Когда необходимо дифференцировать кровохарканье от рвоты с кровью или от кровотечения из носоглотоки или ротоглотки, проводится осмотр глотки, гортани и дыхательных путей с помощью волоконной оптики, а также пищеводно-желудочная экндоскопия.
Проводятся также лабораторные исследования. Пациентам обычно проводят общий анализ крови с подсчетом количества тромбоцитов, определение ПВ (протромбинового времени) и АЧТВ (активированного частичного тромбопластинового времени). Пациентам, получающим низкомолекулярный гепарин, проводится анализ на выявление антифактора Xa. Для определения признаков гломерулонефрита (гематурия, протеинурия, цилиндры) выполняют общий анализ мочи. Реакция Манту и посев мокроты проводятся в качестве начальных тестов на выявление активного туберкулеза, однако отрицательные результаты не исключают необходимости индуцировать мокроту или провести бронхоскопию для получения образцов с целью исследования на кислотоустойчивые бактерии, если альтернативный диагноз не выявлен.
Криптогенное кровохарканье
В 30–40% случаев причину кровохарканья установить не удается, но прогноз у пациентов с криптогенным кровохарканьем в целом благоприятный, обычно кровохарканье разрешается в течение 6 месяцев.
Носовое кровотечение. Кровохарканье, легочное кровотечение.
Носовое кровотечение. Кровохарканье, легочное кровотечение.
Причины носовых кровотечений весьма разнообразны и приведены в таблице.
Диагноз носового кровотечения обычно не труден. Важно выяснить причину, вызвавшую кровотечение, так как в ряде случаев лишь эффективное лечение основного заболевания может остановить и предупредить носовые кровотечения.
Наиболее частые причины носовых кровотечений
| Механические повреждения | Травмы носа, переломы черепа, грубое удаление корок слизистой, расчесы слизистой |
| «Местные» заболевания носа | Полипы, язвы перегородки носа. Опухоли носа |
| Общие (соматические) заболевания | Гипертоническая болезнь, лейкозы, геморрагические диатезы, болезнь Рандю-Ослера, гепатиты, циррозы печени, нефрит, пороки сердца с нарушением кровообращения и др. |
| Инфекционные заболевания | Грипп, скарлатина, геморрагическая лихорадка |
| Медикаментозного генеза (ятрогенные) | Передозировка антикоагулянтов |
Кровохарканье, легочное кровотечение
Наиболее частые причины кровохарканья и легочных кровотечений приведены в таблице.
Во врачебной практике под кровохарканьем обычно понимают выделение с кашлем крови - прожилки крови в мокроте или плевки с кровью. Выделение с кашлем большого количества крови обозначают как легочное кровотечение. Однако разделение на кровохарканье и легочное кровотечение весьма относительно.
Наиболее частые причины кровохарканья, легочного кровотечения
| Механические повреждения | Травмы грудной клетки, плевры, легких. Баротравмы легких |
| Заболевания легких | Пневмония, туберкулез, бронхоэктазы, абсцесс, рак, гангрена, инфаркт легких |
| Заболевания сердечнососудистой системы (с нарушением кровообращения) | Пороки сердца (особенно часто митральный стеноз), гипертоническая болезнь, ишемическая болезнь сердца, миокардиты |
| Заболевания системы крови | Лейкозы, геморрагические диатезы |
| Лекарственные | Передозировка антикоагулянтов |
| Прочие заболевания | Синдром Вегенера, Гудпасчера и др. |
При кровохарканье и легочном кровотечении кровь алая и пенистая и появляется обычно после кашля (нередко после приступов кашля). Величина кровотечения в значительной мере зависит от калибра поврежденного сосуда или степени застоя в малом круге кровообращения.
Кровохарканье и легочное кровотечение часто являются осложнением какого-либо заболевания, особенно часто - органов дыхания. Поэтому кровохарканье и легочное кровотечение нередко появляются на фоне клиники этого заболевания, дополняя ее. Например, бронхоэктатическая болезнь со своей типичной клиникой и кровохарканье; абсцесс легкого и легочное кровотечение; митральный стеноз и кровохарканье и т.д. Нередко кровохарканье является первым клиническим признаком возникшего или развивающегося заболевания (например, кровохарканье при туберкулезе легких, опухоли легких и т.д.).
Диагностика легочных кровотечений обычно не трудна. Большое значение в распознавании принадлежит анамнезу. Следует подробно расспросить больного (или его родственников) о всех деталях кровотечения: когда произошло кровохарканье, выделилась ли кровь с кашлем или без него, каков был вид крови (алый, темный), впервые произошло кровотечение или подобные кровотечения были и раньше, как много терялось крови во время последнего кровохарканья и во время прошлых кровотечений и т.п. Большое значение имеет выяснение в анамнезе перенесенных заболеваний органов дыхания, кровообращения и т.д., которые могут сопровождаться кровотечением. Кровь, выделяющаяся из легких, алая, пенистая и длительно не свертывается, появляется после кашля. Однако алая (ярко-красная) кровь наблюдается иногда при кровавой рвоте (артериальное желудочное кровотечение) и кровотечении из расширенных вен пищевода. С другой стороны, при обильном кровотечении из верхних дыхательных путей одновременно с откашливанием происходит и заглатывание крови и скопление ее в желудке. Это может привести к кровавой рвоте. В таких случаях клиническая картина становится более сложной и определить характер и локализацию кровотечения бывает затруднительно.
Информация на сайте подлежит консультации лечащим врачом и не заменяет очной консультации с ним.
См. подробнее в пользовательском соглашении.
Легочное кровотечение
Легочное кровотечение - клинический синдром, характеризующийся поступлением крови в трахеобронхиальное дерево, с последующим ее откашливанием, в результате различных заболеваний. По данным Ассоциации торакальных хирургов России причиной развития легочного кровотечения может быть около 50 различных заболеваний и синдромов. В XX веке, в нашей стране, наиболее частой причиной развития легочного кровотечения являлся туберкулез, на втором месте располагались различные гнойно-деструктивные процессы в легочной ткани. В последние 20-30 лет, в следствие улучшения эпидемиологической обстановки, на первое место выходят легочные кровотечения, обусловленные онкологическими заболеваниями легких. При этом легочные кровотечения при воспалительных заболеваниях дыхательных путей не утратили своей значимости, и достаточно часто являются причиной экстренных госпитализаций в хирургические стационары.
Частота легочных кровотечений составляет 1–4% от числа всех кровотечений у пациентов, госпитализированных в многопрофильные стационары, при этом летальность, по данным различных авторов, колеблется в диапазоне 30-80%. Как было указано выше, легочное кровотечение не является самостоятельной патологией, а рассматривается как следствие различных заболеваний, не только дыхательной, но и сердеч н о-сосудистой систем, а также аномалий и пороков развития. В настоящее время одной из основных причин развития легочного кровотечения являются опухолевые процессы в бронхолегочной системе. Следует отметить, что у 7-10% больных раком легкого первым проявлением заболевания является именно легочное кровотечение. Как и в случаях с легочными кровотечениями иной этиологии, при злокачественных опухолях легких оно может проявляться как кровохарканьем (появление прожилок или сгустков крови в мокроте), так и откашливанием крови в большом объеме. В то же время даже минимальное кровохарканье может служить предвестником массивного легочного кровотечения.
В отечественной и зарубежной литературе разработано большое количество различных классификаций лёгочного кровотечения. Наибольшее значение в клинической практике имеет классификация, предложенная в 1990 году Е.Г. Григорьевым, в основе которой лежит зависимость объема кровотечения от скорости кровопотери.
100 мл одномоментно
Более 100 мл и/или обструкция ТБД, асфиксия
Диагностика легочного кровотечения
Диагностика легочного кровотечения достаточно сложна, поскольку требует рассмотрения большого дифференциально-диагностического ряда, который обычно проводится между носовым кровотечением, с последующим затёком крови в нижние дыхательные пути, кровотечением из полости рта, желудочно-кишечным кровотечением, сопровождающиеся аспирацией крови в дыхательные пути. Поэтому, прежде чем проводить углублённые, нередко инвазивные исследования, необходимо выполнить тщательный физикальный осмотр пациента, а также подробный сбор анамнеза, с комплексной оценкой данных лабораторных исследований.
Принципиально важно на этапе осмотра пациента дифференцировать легочное кровотечение и кровотечение из желудочно-кишечного тракта (ЖКК). Кровотечения из ЖКТ сопровождаются следующим набором клинических и анамнестических признаков: наличие язвенной болезни в анамнезе, рвота неизмененной кровью или по типу «кофейной гущи», черный стул (мелена). Следует отметить, что достаточно часто массивные ЖКК могут «маскироваться» под легочное кровотечение, по причине аспирации крови в трахеобронхиальное дерево, с дальнейшим ее откашливанием.
КТ-картина имбибиции верхней доли правого легкого
Золотым стандартом в диагностике легочного кровотечения является выполнение компьютерной томографии с внутренним контрастированием (Ангио-КТ), позволяющее как оценить состояние легочной паренхимы, так и определить локализацию субстрата для кровотечения, а также выявить патологические бронхиальные артерии, диагностировать аномалии и пороки развития легких и их сосудов. Одной из важнейших задач при выполнении Ангио-КТ является оценка проходимости ветвей легочной артерии, поскольку нередко легочное кровотечение является следствием развития ТЭЛА, и подходы к лечению таких пациентов принципиально отличаются. В тоже время, противопоказаний к выполнению экстренной Анго-КТ немного, и для их выявления, порой, достаточно подробного сбора анамнеза и выполнения биохимического анализа крови.
Лечение легочного кровотечения
Лечение легочного кровотечения многокомпонентное, и должно начинаться как на доврачебном этапе, так и в условиях скорой медицинской помощи. После подтверждения диагноза легочного кровотечения лечением больного должен заниматься врач-торакальный хирург, поскольку в его арсенале доступны все лечебные и диагностические методы. Уже на этапе диагностики назначается консервативная гемостатическая, гипотензивная терапия. При легочных кровотечениях из большого круга кровообращения 1 ст. (наиболее часто встречающихся), данной терапии бывает достаточно для его надежной остановки.
Фибробронхоскопия (ФБС) - исследование, в основе которого лежит визуальная оценка состояния слизистой оболочки гортани, трахеобронхиального дерева, ФБС - единственная методика, с помощью которой можно надежно визуализировать источник кровотечения. Однако следует отметить, что ФБС - инвазивное исследование, требующее определенной подготовки пациента.
![]() | ![]() |
Ригидная бронхоскопия с клапанной бронхоблокацией правого верхнедолевого бронха

Патологически расширенная правая бронхиальная артерия
Учитывая вышеуказанное, диагностика легочного кровотечения, как правило, требует выполнения ригидной̆ бронхоскопии, позволяющие не только минимизировать риск развития асфиксии, но и выполнить ряд лечебных мероприятий. Выполняемая при ригидной бронхоскопии клапанная бронхоблокация позволяет добиться надежного временного гемостаза и практически полностью исключает риск развития фатальных осложнений.В случаях легочного кровотечения большего объема (2-3 ст.) выбор лечебной тактики зависит, как правило, от основного заболевания. Источником кровотечения из большого круга кровообращения служат бронхиальные артерии, являющиеся основой артериального кровоснабжения легочной паренхимы.

Видеоторакоскопическая расширенная комбинированная бронхопластическая лобэктомия у пациента с центральным раком левого легкого, осложненного легочным кровотечением Обычный диаметр этих артерий менее 1 мм. Любые визуализируемые по данным Ангио-КТ бронхиальные артерии могут считаться патологически расширенными. При легочных кровотечениях любого объема, с наличием патологических бронхиальных артерий, рентгенэндоваскулярные вмешательства могут быть методом выбора как дополнительной диагностики, так и радикального гемостаза.
Непосредственным методом гемостаза является эмболизация бронхиальных артерий. По данным литературы эффективность рентгенэндоваскулярной эмболиации бронхиальных артерий составляет около 97%.
С учетом развития эндобронхиальной и рентгенэдваскулярной хирургии для достижения надежного гемостаза доля резекционной хирургии легких сводится к минимуму. Однако необходимо понимать, что в некоторых клинических ситуациях, например, легочных кровотечений на фоне онкологического заболевания, особенно при резектабельных опухолях, именно хирургическое вмешательство на легком рассматривается не только как окончательный вариант гемостаза, но и как оптимальный радикальный объем хирургического лечения по современным онкологическим стандартам.
На базе Центра интенсивной пульмонологии и торакальной хирургии СПбГБУЗ«ГМПБ№2» осуществляется ежедневное оказание неотложной помощи больным с легочными кровотечениями. Многолетний опыт работы, наличие в арсенале Центра современного оборудования и новейших технологий для диагностики и лечения этих состояний позволяет оказывать медицинскую помощь на уровне мировых экспертных центров.
Кровохарканье и легочное кровотечение

Помощь при кровохарканье и легочном кровотечении
Кровохарканье - выделение крови или мокроты с примесью крови из дыхательных путей при кашле. Кровь может располагаться в мокроте равномерно и тогда вся мокрота равномерно прокрашивается красным, розовым или бурым цветом в зависимости от заболевания и имеет при этом желеобразный или пенистый вид, а может располагаться в виде отдельных прожилок. Иногда за кровохарканье принимают наличие в слюне примеси крови, источниками которой являются кровоточащие десны или носовое кровотечение.
Легочное кровотечение - выделение через дыхательные пути значительного количества крови либо во время кашля, либо без кашля, когда кровь вытекает из дыхательных путей в полость рта струей. Сильное легочное кровотечение (более 240 мл крови в течение 24 часов) представляет непосредственную опасность для жизни больного. Наиболее частыми причинами легочного кровотечения являются туберкулез и рак легких. Кровь, выделяемая при легочном кровотечении, алого цвета, пенистая и не свертывается.
Как кровохарканье, так и легочное кровотечение требуют неотложной помощи и чаще всего являются показаниями для экстренной госпитализации в стационар и срочного врачебного вмешательства.
Помощь при кровохарканье и легочном кровотечении
Больному необходимо обеспечить полный физический покой. Необходимо усадить больного в кровати в полусидячем положении с наклоном в пораженную сторону для того, чтобы избежать попадания крови в здоровое легкое. На пораженную половину грудной клетки кладут пузырь со льдом. Больному дают проглатывать небольшие кусочки льда, что приводит к рефлекторному спазму и уменьшению кровенаполнения кровеносных сосудов легких. Кровохарканье, а тем более, легочное кровотечение сопровождается бурной эмоциональной реакцией страха, как самого больного, так и его близких, особенно, если оно возникло впервые. В связи с этим необходимо постараться успокоить больного и его близких, вселив уверенность в отсутствии реальной опасности для жизни. Для уменьшения эмоциональной реакции со стороны больного и его близких рекомендуется использование постельного и нательного белья, а также платков и полотенец не белого, а темных цветов, например, зеленого, на которых кровь не так заметна и выглядит темными, а не красными пятнами. Если кровохарканье или легочное кровотечение сопровождается кашлем необходимо дать больному по назначению врача противокашлевые средства. Воздействие высокой температуры может спровоцировать усиление кровотечения. Поэтому больной может есть только холодную и полужидкую пищу. Категорически запрещается применение горячей ванны или душа, постановка банок, горчичников, грелок и горячих компрессов на грудную клетку. До осмотра врачом больному нельзя двигаться и разговаривать.
Легочное кровотечение
Кровохарканье довольно типично для рака лёгкого, рано или поздно оно возникает почти у половины больных. Кровохарканье — это кровь в мокроте в каждом плевке или реже, прожилками или полностью смешанная со слизью, но не более 50 мл в сутки. Больше крови в мокроте — признак лёгочного кровотечения. В методичках для торакальных хирургов лёгочное кровотечение (ЛК) обозначают, как «откашливание крови, которое проявляется кровохарканьем или кровотечением».

Кровохарканье может быть довольно длительным. Оно не отражается на состоянии больного, но психологически угнетает. Кровотечение не только ухудшает состояние и все показатели функций организма, но может угрожать жизни.
Лёгочное кровотечение бывает разной интенсивности, специалисты по-разному оценивают его массивность, где-то массивным кровотечением считают суточную потерю стандартного медицинского лотка крови — 600 мл, где-то — более литра.
Виды легочного кровотечения
Отечественные специалисты с 1990 года пользуются классификацией лёгочного кровотечения по трём степеням:
- Первая, А, Б и В — последовательно от 50 до 500 мл суточной потери крови;
- Вторая, А и Б — от 30 мл до 500 мл уже за час;
- Третья степень, А и Б — одномоментно излитие до 100 мл крови или более.
Тактика при разной интенсивности кровопотери различается, и если кровохарканье у пациента не пугает онколога, хоть и вносит коррективы в терапию, то кровотечение из лёгкого требует срочной медицинской и реанимационной помощи.
Как возникает лёгочное кровотечение?
Принципиально кровохарканье возможно при любой серьёзной патологии лёгких и даже при банальном бронхите, при инфекциях и заболеваниях сердца. Но причиной кровотечения из сосудов лёгочных структур чаще всего становятся злокачественные опухоли бронхов. Далее следуют первичные опухоли самой ткани лёгкого и метастазы в лёгкие злокачественных опухолей любых органов. У каждого десятого больного раком лёгкого кровотечение — первый явный симптом болезни, но в среднем кровотечение разной интенсивности в процессе болезни настигает каждого пятого пациента.
При раке причина кровотечения кроется в разъеденном опухолью сосуде. Раковая опухоль распространяется в окружающие ткани, прорастая их, замещая нормальные ткани опухолевой. Бронхиальная стенка пронизана сосудиками, которые тоже вовлекаются в опухоль, опухоль как будто «съедает» их, образуя дефект сосудистой стенки, легко пробиваемый током крови. Стенки разорванного сосуда не могут спадаться, поскольку неподвижны из-за окружающей опухоли каменистой плотности. Сосуд зияет своим просветом, из него беспрепятственно кровь изливается в просвет бронха и кашлевым рефлексом выбрасывается наружу. Дефект сосудистой стенки может быть крошечным, но чем больше диаметр повреждённого сосуда, тем интенсивнее кровотечение.

До 80% лёгочных кровотечений отвечают критериям первой степени тяжести. Массивные кровотечения, их даже называют молниеносными из-за потери крови «полным ртом», отмечаются только у пяти из сотни, но выживают при таком кровотечении единицы. Повезло, если кровотечение случилось в стационаре, потому что в течение первого часа от начала кровотечения без медицинской помощи погибает две трети больных.
Любое случившееся дома кровотечение — беда, лёгочное кровотечение — страшная трагедия, потому что для такого случая просто жизненно необходима срочная эвакуация в специализированное реанимационное отделение. Из доехавших до обычной больницы пациентов тоже выживают только единицы. И погибают они не столько от кровопотери, сколь от асфиксии — заполнения лёгочных альвеол стекающей по бронхам кровью, что нарушает газообмен, а без кислорода жизни нет.
Симптомы легочного кровотечения
Кровотечение может случиться в любое время и даже вовсе беспричинно на фоне полного покоя или умеренной нагрузки. Всё дальнейшее зависит от скорости кровопотери. Если и раньше уже отмечалось кровохарканье, то пациент пугается меньше, но когда кровь идёт горлом страшно всем.
Как правило, при серьёзном кровотечении начинается сильный и неукротимый кашель, к нему присоединяется прогрессирующая одышка, поскольку кровь затекает в альвеолы и отключает в них газообмен. Кровь может пениться, смешиваясь с воздухом. Часто возникает рвота проглоченной кровью, в отторгнутых массах кровь рыжая. Усиливается сердцебиение, пациент покрывается липким холодным потом, руки и ноги холодеют вследствие снижения периферического давления. Уходит кровь, теряются силы.
Диагностика
Для начала необходимо разобраться, действительно ли это лёгочное кровотечение. Установить, что кровит слизистая оболочка ротовой полости или верхних дыхательных путей, помогает ЛОР- осмотр. Далее дифференцируют желудочное и лёгочное кровотечение, при кровотечении из лёгких кровь частично проглатывается и часто бывает рвота, но никогда не бывает жидкого чёрного стула — мелены. Цвет крови не помогает диагностике, потому что кровь из лёгких может быть алой и тёмной, в зависимости от того что повреждено: бронхиальная артерия или веточка лёгочной артерии. Но кровь из лёгких щелочная, а желудочная имеет кислую реакцию рН, это очень быстрая и точная диагностика.
Рентгенологическое исследование органов грудной клетки помогает в половине случаев установить из какого именно лёгкого, правого или левого, поступает кровь, ещё в половине случаев не удаётся локализовать источник. Компьютерная томография с контрастированием тоже установит сторону поражения, а также даст полезную информацию о состоянии систем сосудов бронхиального и малого круга, и чаще рентгена устанавливает точное место, откуда поступает кровь.

Если КТ не смогла найти источник кровотечения, то выполняется бронхоскопия. На первом этапе бронхоскопию выполняют при угрозе жизни, она не столь диагностическое, сколь экстренное лечебное мероприятие. При небольшом кровотечении и при заведомо известном источнике, к примеру, при диагностированной единственной опухоли бронха, просто незаменима ангиография, которая точно укажет на сосуд.
Всё обследование должно выполняться в реанимационном отделении или операционной, поскольку у пациента развивается тяжёлая дыхательная и присоединяется сердечно-сосудистая недостаточность. Важно, чтобы в этот момент рядом с пациентом были реаниматолог, торакальный онколог, сосудистый хирург и рентгенэндоваскулярный хирург. В государственных неспециализированных учреждениях «скорой помощи» нет возможности для оказания достаточной при легочном кровотечении помощи, остаётся полагаться только на искусство хирурга и мастерство реаниматолога.
Лечение лёгочного кровотечения
Поскольку половина пациентов к моменту развития лёгочного кровотечения уже прошла лечение первичного рака лёгкого и вступила в период его неуклонного прогрессирования, такие радикальные меры лечения кровотечения, как удаление части или всего лёгкого, у них невозможны. Разумеется, если лёгочное кровотечение выступает первым сигналом о наличии злокачественной опухоли лёгкого или бронха, необходимо решить вопрос о возможности радикальной операции, если другими консервативными способами не удаётся остановить кровь. Плановая операция имеет неоспоримые преимущества, срочное вмешательство имеет целью спасение жизни.

При небольшом кровотечении сначала прибегают к консервативной терапии, с назначением противокашлевых препаратов. При значительном кровотечении на первый план выходят методы интервенционной эндоскопии, но сначала больного вводят в наркозный сон и интубируют трахею. При бронхоскопии воздействуют на источник кровотечения, если таковой найден, а до того промывают бронхи холодными растворами, вводят кровоостанавливающие средства.
Повреждённый сосуд коагулируют или устанавливают в бронхе баллон или тампон на 1-2 суток. Возможна электрокоагуляция, лазерная фотокоагуляция и аргон-плазменная коагуляция повреждённого сосуда. При отсутствии информации о точном нахождении источника кровотечения выполняется эмболизация бронхиальных артерий. Специализированным отделениям доступен мультимодальный подход, когда выполняется коагуляция и эндопротезирование, а после остановки кровотечения на опухоль проводится фотодинамическая терапия и брахитерапия. Этот подход даёт самую высокую отдалённую выживаемость.
Современная медицинская наука предлагает выбор – дело за возможностями конкретного учреждения, в которое направлен пациент.
Читайте также:


